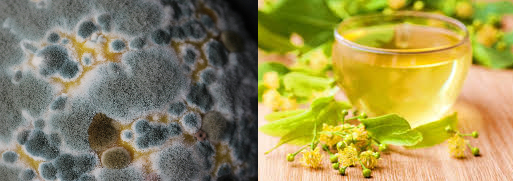

Я был неправ
16.11.2025 12:00
6029
Комментарии (84)
Должен признаться - я был неправ, приводя вот этот отрывок из киношлака некоей Марии Ефремовой как пример лютой кринжатины.
Самая кринжатина там, как выяснилось, совсем в другом, тот отрывок - еще цветочки!
Мужественная Люся Грин посмотрела эту дичь целиком, и нашла там значительно более вставляющие эпизоды - от отметки 09:40, если кому интересно.
Войдите, чтобы оставить комментарий.
С пикабы:
В целом полное ощущение, что весь фильм зритель находится в голове Александра Проханова. Едва ли Мария Ефремова рассчитывала в своем творчестве на такую степень погружения
В целом полное ощущение, что весь фильм зритель находится в голове Александра Проханова. Едва ли Мария Ефремова рассчитывала в своем творчестве на такую степень погружения
Между прочим нетривиальная задача по физике - тонет ли оно в нём?
Вот вы ржёте, а они опять всю воду выпили. На этот раз - в Иране.
И облака дождевые воруют
В Тегеране нет воды - ...
Я все таки нащел где это посмотреть. Ожидаемое дерьмо, ничем не лучще предыдущих фильмов, пропитанных антисемитизмом, шовинизмом, нацизмом. Но к счастью, это никто не смотрит, судя по количеству местной в ВК аудитории - несколько человек. А расписывать самое самое обсуждение можно сколько угодно. Но один момент в фильме дико повеселил. Это группа захвата, состоящая из 3!!! Человек!!! Их меньше чем тех кого они освобождали!!! Помните образцовую группу захвата из фильма Леон? Там было 200, может 300 человек. Тем и отличается хорошее кино от голимых подделок. Написал в ВК ефремовой - лучще всего прекрати снимать это антисемитское дерьмо и иди работать продавщицей, они везде нужны
лучще
Написал в ВК ефремовой - лучще всего прекрати снимать это антисемитское дерьмо и иди работать продавщицей, они везде нужны
И как - послушалась она вашего совета?
По логике, дальше в этом кино должны появиться рептилоиды.
На всем лежит еврейский глаз,
у всех еврейские ужимки,
и с неба сыпятся на нас
шестиконечные снежинки.
И. Губерман
у всех еврейские ужимки,
и с неба сыпятся на нас
шестиконечные снежинки.
И. Губерман
За все на евреев найдется судья.
За живость. За ум. За сутулость.
За то, что еврейка стреляла в вождя.
За то, что она промахнулась.
(С) он же
За живость. За ум. За сутулость.
За то, что еврейка стреляла в вождя.
За то, что она промахнулась.
(С) он же
А Маше не прилетит за оскорбление чувств верующих? Неужели никто не пожалуется? 🤔
Бывают фильмы с отвратительным посылом, но в чем то другом сделанные хорошо. Например небезызвестный Бумер. В нем хорошо играют, интересный сюжет и отличный саундтрек.
В этом же кино плохо все. Если задуматься, то возможно это к лучшему.
В этом же кино плохо все. Если задуматься, то возможно это к лучшему.
Бумер
И нормальный посыл, не отвратительный.
Сделано так, чтобы зритель сопереживал этим 4ым персонажам, которым сопереживать объективно не стоит.
Нет, так не сделано, этот трюк был использован в "Бригаде". В "Бумере" все показанно довольно честно, понты могут привести к беде, дружба забывается когда припрет, главные герои самые обыкновенные балаболы и опасные идиоты.
И Чебурашку подкинули!
PS Передайте этому свино-колобку Андрюше Макарову, что апельсины шли ещё и из Марокко, а после разрыва дип отношений только из него и др африканских стран. Пусть Василия Аксенова читает.
PS Передайте этому свино-колобку Андрюше Макарову, что апельсины шли ещё и из Марокко, а после разрыва дип отношений только из него и др африканских стран. Пусть Василия Аксенова читает.
что апельсины шли ещё и из Марокко, а после разрыва дип отношений только из него
В ЖЖ написано, значит правда. Там врать не будут!
что апельсины шли ещё и из Марокко, а после разрыва дип отношений только
апельсины шли ещё и из Марокко
Ни разу не видел тот чёрный ромбик на апельсинах. Только на мандаринках.
Было написано Marocco?
От черт. Не успел 😄
"Как полтора процента евреев занимает девяносто процентов руководящих должностей?"
Ну, допустим, не девяносто и не руководящих. Но в науке, творческой культуре таки да. И тут у меня родилось страшное подозрение: это потому, что они умнее! Вот они какие коварные!
Ну, допустим, не девяносто и не руководящих. Но в науке, творческой культуре таки да. И тут у меня родилось страшное подозрение: это потому, что они умнее! Вот они какие коварные!
родилось страшное подозрение: это потому, что они умнее! Вот они какие коварные!
Исторически им запрещали заниматься чем-то другим, кроме работы мозгами. Пришлось крутитсья!
Но если это у тебя хохма про евреев, что в переводе с иврита на русский мудрость, то принимается.
Балда, в смысле?
Балда, в смысле?
Исторически им запрещали заниматься чем-то другим, кроме работы мозгами
По русски хохма это шутка, слово пришло из иврита, а котором хохма означает мудрость.
То, что ты это знаешь - это плюс. То, что ты не знаешь, что с балдой аналогичная история - это минус.
Что именно? Что в лугандоне их 99% осталось. А если учесть понаехавшее кацапье то еще больше
Что именно? Что в лугандоне их 99% осталось. А если учесть понаехавшее кацапье то еще больше
слово «балда» Волька трактует Хоттабычу как слово, обозначающее мудреца, только потому, что с иврита «баал дат» и правда переводится как «муж знания и веры».
Ага, в ПТУ запрещали поступать, дабы не допустить растления рабочего класса сионистской идеологией!
слово «балда» Волька трактует Хоттабычу как слово, обозначающее мудреца, только потому, что с иврита «баал дат» и правда переводится как «муж знания и веры».
Так что ничего общего с мудростью и вообще натягивание совы на глобус
Волька трактует Хоттабычу
Если не ошибаюсь, в книге еще и брат Гассана Абдуррахмана ибн Хаттаба (Хоттабыча) Омар Юсуф ибн Хаттаб произносит заклинание на иврите.
Мопед не мой. За что купил, за то и продал. Ссылка выше.
И чё, Ле-ша? Много у тебя ещё баек про евреев?
Мопед не мой. За что купил, за то и продал. Ссылка выше.
А я писал про одну линию? 🤔 Я знаю обе свои линии до пра-пра.
А нафиг он мне нужен? Идиш немного. Но это язык моих бабушек.
Ага, в ПТУ запрещали поступать, дабы не допустить растления рабочего класса сионистской идеологией!
Поздравляю с очередной посадкой в лужу.
The main Hebrew word for knowledge is דעת (da'at).
Baal da'at - "господин знаний" , т. е. знаток.
Сильно подозреваю, что и "хохма", и "балда" были заимствованы в русский через идиш. Моя собственная бабушка частенько вворачивала в разговор словечки из идиша, причем сплошь и рядом в ироническом смысле.
The main Hebrew word for knowledge is דעת (da'at).
Baal da'at - "господин знаний" , т. е. знаток.
Сильно подозреваю, что и "хохма", и "балда" были заимствованы в русский через идиш. Моя собственная бабушка частенько вворачивала в разговор словечки из идиша, причем сплошь и рядом в ироническом смысле.
Сильно подозреваю, что и "хохма", и "балда"
А тюркские "балта" и "баялды"?
В словах бааль даат нет значения знание, переводится как верующий.
Так что ничего общего с мудростью и вообще натягивание совы на глобус
Так что ничего общего с мудростью и вообще натягивание совы на глобус
(и куда только из ветки все израильтяне делись?)
Бааль что-то-там (свойство или объект) - конструкция современного иврита.
Бааль - господин/муж/владелец
Бааль аДира - квартирный хозяин, который, сцуко, каждый месяц за бабками приходит! 😉
Бааль нисайон - опытный, бааль хаим - животное (обладатель жизни), бааль микцоа - профессионал (обладатель профессии) и так далее..
"Знающий" сейчас скажут скорее "балль йеда", но и "бааль дат" тоже можно. "йеда" - просто знание, а "дат" - вычурно, скорее мудрость. Религиозный человек = "бен адам дати".
оборот "бааль дат" в значении "мудрец" это стилизация под танахический иврит, но не оттуда. Вполне в стиле "Старика Хоттабыча" 😉.
И конечно хохмА, с ударением на А, это мудрость. "Ат яфА ве-хахамА" = ты красивая и умная. 😉
Меня сам Георгий Климов пытался кусать - ничего не вышло. Объяснение требует много букв, поэтому уж извините, его не будет.
Меня сам Георгий Климов пытался кусать
Бааль колец?
Бааль колец?
Не понятна тяга людей быть экспертами в сортах говна.
Может быть в попытке помешать говну захлестнуть всё?
Точно! Без знающих людей трудно разобраться.
Кстати, Люся Грин не совсем до конца насчёт Ленина права. Нет, посыл у неё верный. Но чисто справедливости ради, там всё-таки не только одна голова. Цитирую, что подсказывает Яндекс.Алиса:
Да, в Мавзолее лежит только часть тела Владимира Ленина — около 20%, а именно голова, руки и шея.
Ноги и туловище Ленина удалили, чтобы избежать возможных необратимых процессов разложения. Их не утилизировали и не захоронили, а сохранили в качестве биоматериала, с помощью которого можно в будущем восстанавливать утраченные фрагменты кожи.
Да, в Мавзолее лежит только часть тела Владимира Ленина — около 20%, а именно голова, руки и шея.
Ноги и туловище Ленина удалили, чтобы избежать возможных необратимых процессов разложения. Их не утилизировали и не захоронили, а сохранили в качестве биоматериала, с помощью которого можно в будущем восстанавливать утраченные фрагменты кожи.
А как же 80% воды?
Куда дели?
Куда дели?
Вот не знал, познавательно.
Да и вообще - похороните Ленина.
Да и вообще - похороните Ленина.
Я начал смотреть с 9:40, но долго не выдержал. Это какой-то не описуемый маразм!
Вот видите, сейчас расцвет не только русской культуры, но и философии. Когда еще в одном поколении присутствуют Дугин и Ефремова.
Человек-Говно хочет стать Гитлером, но так и остаётся говном.
Человек-Говно хочет стать Гитлером, но так и остаётся говном.
Тетка-руководитель заслуженная, идентифицировалa останки Ричарда 3 в Лестере.
Идентифицировала с чем? Есть ещё какой-то научно подтвержденный образец?
Есть ещё какой-то научно подтвержденный образец?
Возможно. Но в Википедии о них ни слова. Я имею в виду детей детей.
И. Прошло минимум двадцать поколений, гены должны были так перемешаться, что от исходного Ричарда там осталось ноль.
И. Прошло минимум двадцать поколений, гены должны были так перемешаться, что от исходного Ричарда там осталось ноль.
Идентифицировала с чем? Есть ещё какой-то научно подтвержденный образец?
Прошло минимум двадцать поколений, гены должны были так перемешаться
Вот тут про их исследования.
Вкратце: мтДНК - полное совпадение, а вот Y - не совпадает, то есть где-то в мужской линии очередному папе наставили рога.
Три не связанных реплики, в одном посте просто чтобы посты не плодить.
=======
1. Этот антисемитский 3.14дец в стиле начала 20 века реально куда-то вышел? Прикольно. Ну с РФ все как-бы ясно, а на ютубе почему это говно болтается? Пойду штоле жалобу кину в ютуб.
---- -------
2. Люся как обычно живет в своем мире, мало связанным с реальностью. Г-н Гундяев говорил про Хрущева. Нет, не про Ленина.
----------
3. Шутки "Камеди клаба" просто не политические, но все равно лучше КВН. Смешно же не только про политику может быть. Марина Кравец вдруг перестала быть смешной? Для всех или только для Люси?
=======
1. Этот антисемитский 3.14дец в стиле начала 20 века реально куда-то вышел? Прикольно. Ну с РФ все как-бы ясно, а на ютубе почему это говно болтается? Пойду штоле жалобу кину в ютуб.
---- -------
2. Люся как обычно живет в своем мире, мало связанным с реальностью. Г-н Гундяев говорил про Хрущева. Нет, не про Ленина.
----------
3. Шутки "Камеди клаба" просто не политические, но все равно лучше КВН. Смешно же не только про политику может быть. Марина Кравец вдруг перестала быть смешной? Для всех или только для Люси?
Марина Кравец вдруг перестала быть смешной?
Со смертью маслякова КВН начал поднимать голову из глубочайшей ямы
Чего только Флеш-Рояль стоит, открывший, как кажется, новую страницу КВН - не источник кадров для стэндапа и развлекательных каналов, без фактической смены формата, а единые, связанные одной мыслью постановки - гораздо более глубокий (высокий) формат, нежели стэндап или развлекательные телешоу
Чего только Флеш-Рояль стоит, открывший, как кажется, новую страницу КВН - не источник кадров для стэндапа и развлекательных каналов, без фактической смены формата, а единые, связанные одной мыслью постановки - гораздо более глубокий (высокий) формат, нежели стэндап или развлекательные телешоу
Со смертью маслякова КВН начал поднимать голову из глубочайшей ямы
2. Люся как обычно живет в своем мире, мало связанным с реальностью. Г-н Гундяев говорил про Хрущева. Нет, не про Ленина.
.=======
1. Этот антисемитский 3.14дец в стиле начала 20 века реально куда-то вышел? Прикольно. Ну с РФ все как-бы ясно, а на ютубе почему это говно болтается? Пойду штоле жалобу кину в ютуб.
1. Этот антисемитский 3.14дец в стиле начала 20 века реально куда-то вышел? Прикольно. Ну с РФ все как-бы ясно, а на ютубе почему это говно болтается? Пойду штоле жалобу кину в ютуб.
Нет, удален отовсюду. Я с трудом в ВК нашел в конфе ее студии Северное Сияние. Оно до сих пор там висит
Ой, а кино с Ютуба уже прибрали.
"Наверное, что-то случилось" (с)
"Наверное, что-то случилось" (с)
Сервера ложились от наплыва ценителей, не иначе.
М-м...
Хрущев в мавзолее?
Хрущев в мавзолее?
М-м...Хрущев в мавзолее?
Не бережёт оно себя совсем. Весь этот фильм даже по рашистскому УК - состав на сразу несколько статей.
Теперь этой гениальной мадам надо всего один раз где-то оступиться (например, поискать в сети экстремистские материалы с сайта иноагента), и местные шакалы её вмиг на доносы раздерут.
Теперь этой гениальной мадам надо всего один раз где-то оступиться (например, поискать в сети экстремистские материалы с сайта иноагента), и местные шакалы её вмиг на доносы раздерут.
Теги
Информация
Что ещё почитать
Обзор часов OnePlus Watch 4 - почти идеальные!
05.05.2026
80
Они придут за тобой
25.05.2026
27